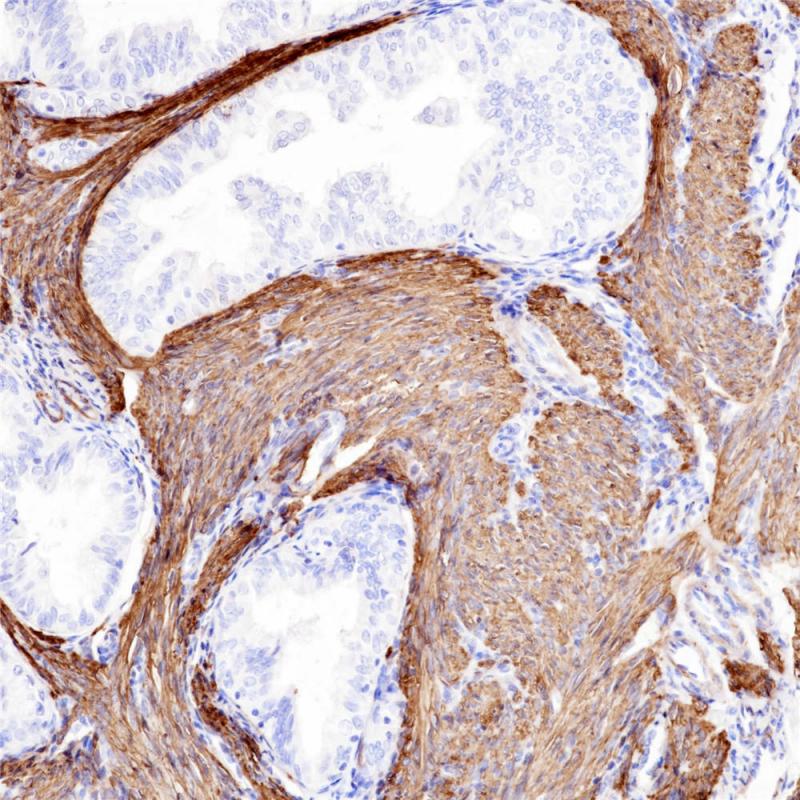
子宫内膜癌Calponin(BP6093)染色

产品中心

前列腺癌Calponin(BP6093)染色
子宫内膜癌Calponin(BP6093)染色
Calponin 重组兔单克隆抗体
Calponin是一种结合原肌球蛋白和F-肌动蛋白的钙调蛋白,是平滑肌细胞的一种特异性蛋白,具有调节平滑肌收缩的功能。Calponin在正常的平滑肌细胞及肌上皮细胞中呈阳性表达,结缔组织增生的间质中肌纤维母细胞会阳性表达。该抗体主要用于平滑肌瘤和乳腺病变中肌上皮细胞的诊断和研究。
Specifications
- 目录号
- BX50088
- 克隆号
- BP6093
- 阳性对照
- 子宫肌瘤
- 亚细胞定位
- 细胞质
- 组织类型
- FFPE
- 修复方式
- HIER
- 稀释比
- 1:100-1:200
- 规格
- 100μl/vial, 1ml/vial
- 用途
- RUO
Reference
1.Mosunjac MB, et al. Diagn Cytopathol. 2000 Sep; 23(3):151-5.
2.Abdulrahman SS, et al. Saudi Dent J 2019 Jan;31(1):105-114.


